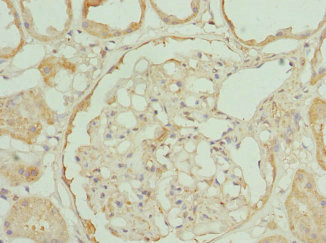

-
中文名稱:RP2兔多克隆抗體
-
貨號:CSB-PA020076ESR1HU
-
規格:¥440
-
圖片:
-
Western blot
All lanes: RP2antibody at 3.81μg/ml
Lane 1: Jurkat whole cell lysate
Lane 2: HepG2 whole cell lysate
Lane 3: Hela whole cell lysate
Secondary
Goat polyclonal to rabbit IgG at 1/10000 dilution
Predicted band size: 40 kDa
Observed band size: 40 kDa -
Immunohistochemistry of paraffin-embedded human kidney tissue using CSB-PA020076ESR1HU at dilution of 1:100
-
-
其他:
產品詳情
-
產品名稱:Rabbit anti-Homo sapiens (Human) RP2 Polyclonal antibody
-
Uniprot No.:
-
基因名:RP2
-
別名:RP2 antibody; Protein XRP2 antibody
-
宿主:Rabbit
-
反應種屬:Human
-
免疫原:Recombinant Human Protein XRP2 protein (1-350AA)
-
免疫原種屬:Homo sapiens (Human)
-
標記方式:Non-conjugated
-
克隆類型:Polyclonal
-
抗體亞型:IgG
-
純化方式:Antigen Affinity Purified
-
濃度:It differs from different batches. Please contact us to confirm it.
-
保存緩沖液:PBS with 0.02% sodium azide, 50% glycerol, pH7.3.
-
產品提供形式:Liquid
-
應用范圍:ELISA, WB, IHC, IP
-
推薦稀釋比:
Application Recommended Dilution WB 1:1000-1:5000 IHC 1:20-1:200 IP 1:200-1:2000 -
Protocols:
-
儲存條件:Upon receipt, store at -20°C or -80°C. Avoid repeated freeze.
-
貨期:Basically, we can dispatch the products out in 1-3 working days after receiving your orders. Delivery time maybe differs from different purchasing way or location, please kindly consult your local distributors for specific delivery time.
-
用途:For Research Use Only. Not for use in diagnostic or therapeutic procedures.
相關產品
靶點詳情
-
功能:Acts as a GTPase-activating protein (GAP) involved in trafficking between the Golgi and the ciliary membrane. Involved in localization of proteins, such as NPHP3, to the cilium membrane by inducing hydrolysis of GTP ARL3, leading to the release of UNC119 (or UNC119B). Acts as a GTPase-activating protein (GAP) for tubulin in concert with tubulin-specific chaperone C, but does not enhance tubulin heterodimerization. Acts as guanine nucleotide dissociation inhibitor towards ADP-ribosylation factor-like proteins.
-
基因功能參考文獻:
- four frameshift mutations including three novel mutations of c.1059 + 1 G > T, c.2002dupC and c.2236_2237del CT, as well as a previously reported mutation of c.2899delG were detected in the RPGR gene in the other four families. Our study further expands the mutation spectrum of RP2 and RPGR, and will be helpful for further study molecular pathogenesis of X-linked retinitis pigmentosa. PMID: 28294154
- RP2 mutation would have a moderate pathogenic effect in photoreceptors carrying the mutation, causing abnormal outer segments, with the accumulation of lipofuscin similar to RDS/PRPH2 pattern dystrophy. PMID: 26885761
- this study identifies ARL3 as a key player in prenylated protein trafficking in rod photoreceptor cells and establishes the potential role for ARL3 dysregulation in the pathogenesis of RP2-related forms of XLRP PMID: 26936825
- Studies indicate taht the majority of patients with X-linked RP have mutations in the retinitis pigmentosa GTPase regulator (RPGR) or retinitis pigmentosa 2 protein (RP2) genes. PMID: 27911705
- study also reveals a role of the C-terminal domain of RP2 in maintaining the overall protein stability. PMID: 28209709
- Three XLRP families (RP-001, RP-002, and RP-003), composed of 13 individuals, were reported in this study, and 2 different mutations were detcted We found 3 genetic variants: a novel mutation c.1591G>T in exon 14 and a novel polymorphism c.1105C>T in exon 10, resulting in p.Glu531* and p.Arg369Cys of RPGR gene, respectively, and one already known mutation c.413A>G in exon 2, resulting in a p.Glu138Gly of RP2 gene PMID: 27768226
- We identified a novel causative mutation in RP2 from a single proband's exome sequence data analysis. This study highlights the effectiveness of the whole-exome sequencing in the genetic diagnosis of X-linked retinitis pigmentosa, over the conventional sequencing methods. PMID: 27769321
- Three mutations were identified in the ORF15 exon of RPGR. No RP2 mutations were found among the examined families. Mutation screening of RP patients is essential to understand the mechanism behind this disease and develop treatments PMID: 27323122
- The ability of the restored RP2 protein level to reverse the observed cellular phenotypes in cells lacking RP2 indicates that translational read-through could be clinically beneficial for patients. PMID: 25292197
- ellipsometric measurements of naRP2 demonstrated that its particular affinity for saturated phospholipids can be explained by its larger extent of insertion in this phospholipid monolayer compared to that in polyunsaturated phospholipid monolayers. PMID: 25844643
- The methylation state of CpG sites close to the RP2 core promoter (GAAA)n repeat serves as a proxy measurement of X-chromosome inactivation in human and non-human primates. PMID: 25078280
- A novel frameshift mutation in RP2 was detected. This mutation was located in exon 2 of the RP2 gene: a nucleotide C was inserted at 111 (c.111insC, Fig. 1A), which caused a protein translation frameshift PMID: 24479636
- Direct sequencing of RPGR and RP2 allowed for identification of a disease-causing mutation in 21 families. Of these "adRP" families 19 had RPGR mutations, and two had RP2 mutations. PMID: 23372056
- Based on our findings, we suggest that RPGR should be considered as a first tier gene for screening isolated males with retinal degeneration. PMID: 23150612
- data support a role for RP2 in facilitating the membrane association and traffic of Gbeta1, potentially prior to the formation of the obligate Gbeta:Ggamma heterodimer; combined with other recent evidence, this suggests that RP2 may co-operate with Arl3 and its effectors in the cilia-associated traffic of G proteins PMID: 22072390
- The localization of RP2 to basal bodies and cilia in photoreceptors and kidney cells has linked RP2 dysfunction with ciliopathies. PMID: 22183373
- Data demonstrate that Importin beta2 is necessary for localization of retinitis pigmentosa 2 (RP2) to the primary cilium, and identify two distinct binding sites of RP2, which interact independently with Importin beta2. PMID: 21285245
- An identifiable phenotype for RP2-X-linked retinitis pigmentosa aids in clinical diagnosis and targeted genetic screening. PMID: 20625056
- We propose that RP2 regulation of Arl3 is important for maintaining Golgi cohesion, facilitating the transport and docking of vesicles and thereby carrying proteins to the base of the photoreceptor connecting cilium for transport to the outer segment. PMID: 20106869
- Our results expand the frequency and spectrum of mutations at RPGR and RP2 as well as their associated clinical phenotypes in Chinese patients. PMID: 20021257
- The mutation 358C-->T is useful in analyzing the function of RP2 protein and gene diagnosis of X-linked retinitis pigmentosa (XLRP). PMID: 11798852
- functional overlap with tubulin-specific chaperone cofactor C PMID: 11847227
- A comprehensive mutation analysis of RP2 and RPGR in a North American cohort of families with X-linked retinitis pigmentosa. PMID: 11992260
- Patients with RP2 mutations had, on average, lower visual acuity but similar visual field area, final dark-adapted threshold, and 30-Hz ERG amplitude compared with those with RPGR mutations PMID: 14564670
- Mutations in the RP2 gene is associated with X-linked retinitis pigmentosa PMID: 14566651
- The data suggest that RP2 may have previously unrecognized roles as a DNA damage response factor and 3' to 5' exonuclease. PMID: 16457815
- The N-terminal 34 residues and beta helix domain of RP2 are required for interaction with Arl3. PMID: 16472755
- In this cohort of XLRP families, as has happened in previous studies, RP3 also seems to be the most prevalent form of XLRP, and, based on the results, the authors propose a four-step protocol for molecular diagnosis of XLRP families. PMID: 16936086
- Three ORF15 mutations and one RP2 mutation in five Japanese retinitis pigmentosa families. PMID: 17093403
- The proportion of RP2-mediated XLRP in the Danish population is higher and the proportion of RPGR-ORF15 is lower than reported in other studies. PMID: 17724181
- RP2 is an efficient GAP for Arl3, with structural features similar to other GAPs PMID: 18376416
- A transversion (T>A) at position -9 in intron 3 of RP2 causes X-linked retinitis pigmentosa (XLRP) by altering the splicing pattern and highlights the pathogenicity of intronic variants. PMID: 19516003
顯示更多
收起更多
-
相關疾病:Retinitis pigmentosa 2 (RP2)
-
亞細胞定位:Cell membrane; Lipid-anchor; Cytoplasmic side. Cell projection, cilium.
-
蛋白家族:TBCC family
-
組織特異性:Ubiquitous. Expressed in the rod and cone photoreceptors, extending from the tips of the outer segment (OS) through the inner segment (IS) and outer nuclear layer (ONL) and into the synaptic terminals of the outer plexiform layer (ONL). Also detected in t
-
數據庫鏈接:
Most popular with customers
-
-
YWHAB Recombinant Monoclonal Antibody
Applications: ELISA, WB, IHC, IF, FC
Species Reactivity: Human, Mouse, Rat
-
Phospho-YAP1 (S127) Recombinant Monoclonal Antibody
Applications: ELISA, WB, IHC
Species Reactivity: Human
-
-
-
-
-